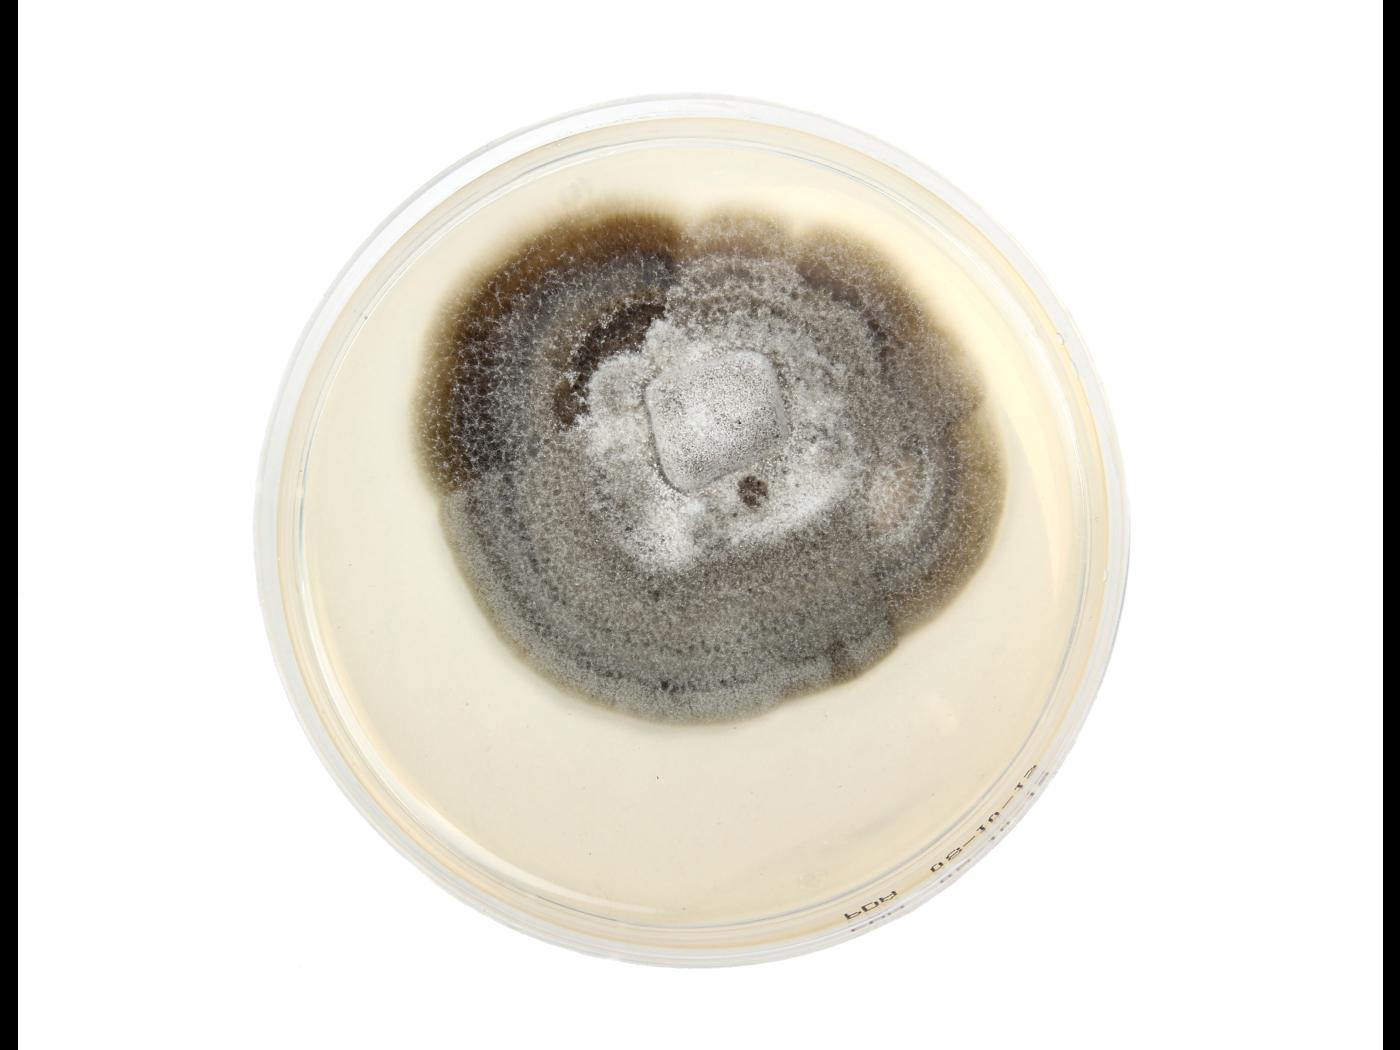

Helminthosporium solani
Informations complémentaires
je n'ai plus accès à cette demande pour vérifier que ce soit vraiment bien H. solani plutôt que Helminthosporium sp. CM
Dommages
Le champignon Helminthosporium solani peut affecter la culture de la pomme de terre.
Références et liens
Cultures ou autres organismes affectés
Maladies parasitaires
Pomme de terre
/index.php/fr/maladies-parasitaires/champignons/helminthosporium-solani/pomme-de-terre-tache-argentee
Pomme de terre - Tache argentée (Helminthosporium solani)_1
Pomme de terre - Tache argentée (Helminthosporium solani)_2
Pomme de terre - Tache argentée (Helminthosporium solani)_3
Pomme de terre - Tache argentée (Helminthosporium solani)_2
Pomme de terre - Tache argentée (Helminthosporium solani)_3